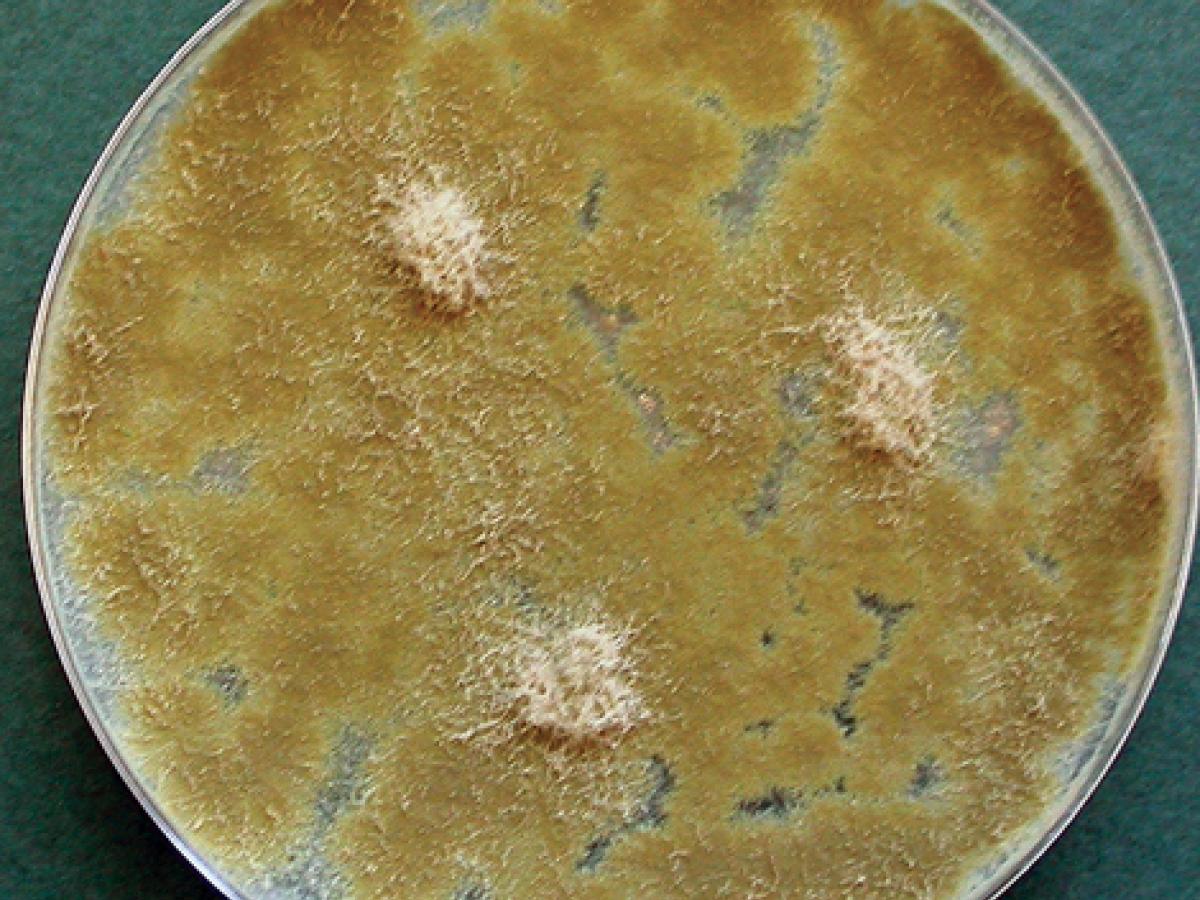
Culture of Paecilomyces variotii

Paecilomyces variotii
Paecilomyces variotii is a common environmental mould that is widespread in composts, soils and food products. It is known from substrates including food, indoor air, wood, soil and carpet dust.
However, P. variotii is an emerging causative agent of mycotic keratitis and of hyalohyphomycosis in the immunocompromised patient. Note: Paecilomyces lilacinus was transferred to Purpureocillium lilacinum (Luangsa-ard et al., 2011); and Paecilomyces marquandii has been transferred to Marquandomyces marquandii (Mongkolsamrit et al., 2020
RG-2 organism.
Culture of Paecilomyces variotii.
Morphological description:
Colonies are fast growing, powdery to suede-like, funiculose or tufted, and yellow-brown or sand-coloured. Conidiophores bearing dense, verticillately arranged branches bearing phialides. Phialides are cylindrical or ellipsoidal, tapering abruptly into a long and cylindrical neck. Conidia are subspherical, ellipsoidal to fusiform, hyaline to yellow, smooth-walled, 3-5 x 2-4 µm and are produced in long divergent chains. Chlamydospores are usually present, singly or in short chains, brown, subspherical to pyriform, 4-8 µm in diameter, thick-walled to slightly verrucose.

Conidiophores, phialides, conidia and terminal chlamydospores of P. variotii.
Molecular identification:
Molecular phylogeny based on 18S rDNA sequences was done by Luangsa-ard et al. (2011). ITS sequencing is recommended for identification.
Key features:
Yellow-brown colony pigmentation, cylindrical phialides, and presence of chlamydospores.
|
Antifungal susceptibility: P. variotii (Australian national data); MIC µg/mL. |
|||||||||||||
|---|---|---|---|---|---|---|---|---|---|---|---|---|---|
| No | ≤0.016 | 0.03 | 0.06 | 0.125 | 0.25 | 0.5 | 1 | 2 | 4 | 8 | 16 | ≥32 | |
| AmB | 45 | 1 | 8 | 8 | 10 | 11 | 4 | 3 | |||||
| ISAV | 10 | 1 | 1 | 1 | 7 | ||||||||
| VORI | 43 | 2 | 2 | 1 | 3 | 4 | 31 | ||||||
| POSA | 42 | 5 | 8 | 7 | 4 | 10 | 5 | 3 | |||||
| ITRA | 45 | 4 | 2 | 7 | 11 | 11 | 7 | 2 | 1 | ||||
References:
- de Hoog, G.S., Guarro, J., Gene, J., et al. (2015) Atlas of Clinical Fungi (Version 4.1.2). Centraalbureau voor Schimmelcultures, Utrecht, The Netherlands.
- Domsch, K.H., Gams, W. and Anderson, T.H. (2007) Compendium of soil fungi. Second Edition, IHW-Verlag, Germany.
- Houbraken, J., Verweij, P.E., Rijs, A.J., et.al. 2010. Identification of Paecilomyces variotii in clinical samples and settings. Journal of Clinical Microbiology, 48, 2754-2761.
- Kidd, S., Halliday, C., Ellis, D. (2023) Descriptions of Medical Fungi (4th edition). CABI.
- Luangsa-ard, J., Houbraken, J., van Doorn, T., et al. (2011) Purpureocillium, a new genus for the medically important Paecilomyces lilacinus. FEMS Microbiology Letters, 321, 141-149.
- Mongkolsamrit, S., Khonsanit, A., Thanakitpipattana, D., et al. (2020) Revisiting Metarhizium and the description of new species from Thailand. Studies in Mycology, 95, 171-251.
- Samson, R.A. (1974) Paecilomyces and some allied hyphomycetes. Studies in Mycology, 6, 1-120.
